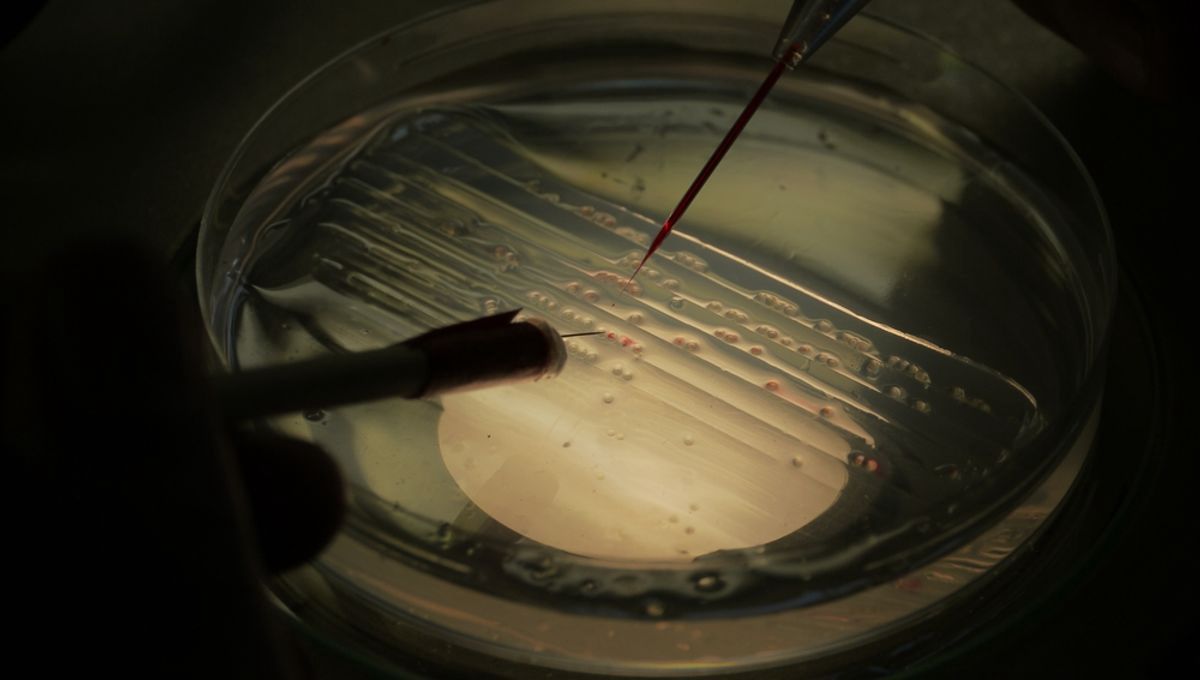

IFLScience
shared a link post in group #IFLScience

www.iflscience.com
Lab-Grown Fish Could Allow Millions Of People To Eat Seafood Again
Fish cells cultivated in the lab appear to have much lower allergen levels.

IFLScience

shared a link post in group #IFLScience
www.iflscience.com
Lab-Grown Fish Could Allow Millions Of People To Eat Seafood Again
Fish cells cultivated in the lab appear to have much lower allergen levels.
Comment here to discuss with all recipients or tap a user's profile image to discuss privately.
<div data-postid="xbookoy" [...] </div>